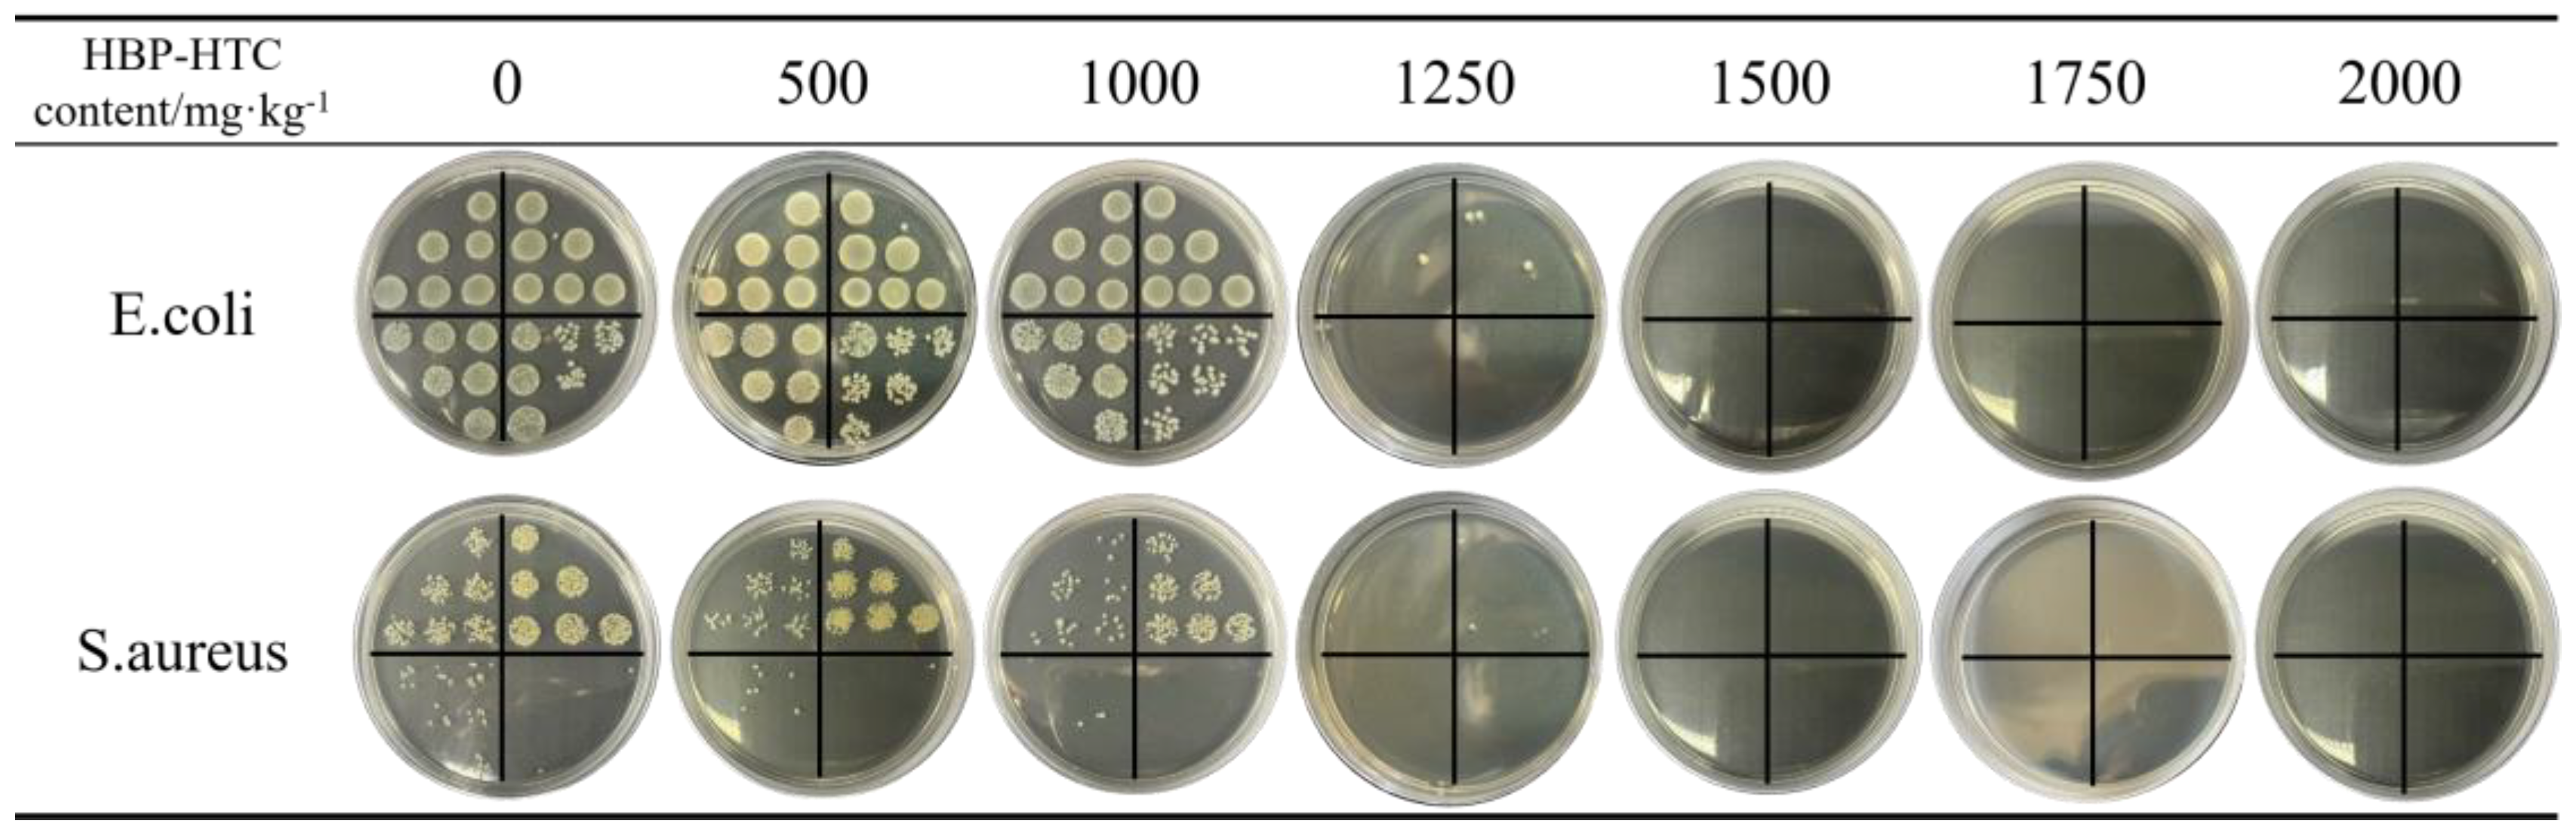
Materials 17 03761 g015

Preparation and Property Analysis of Antibacterial Fiber Membranes Based on Hyperbranched Polymer Quaternary Ammonium Salts
Abstract
1. Introduction
2. Materials and Methods
2.1. Materials
2.2. Synthesis and Characterization of HBP-HTC
2.3. The Preparation and Characterization of the Spinning Solution
2.4. Preparation and Characterization of HBP-HTC/TPU Fiber Membranes
2.5. The Optimization of the Preparation Process of HBP-HTC/TPU Fiber Membranes
- The Effect of the Spinning Voltage on the Surface Structure of the HBP-HTC/TPU Fiber Membrane
- 2.
- The Effect of the Drum Rotation Speed on the Surface Structure of the HBP-HTC/TPU Fiber Membrane
2.6. Antibacterial Tests
2.7. Protective Performance Tests
3. Results and Discussion
3.1. Preparation and Characterization of HBP-HTC
3.2. The Preparation and Characterization of the Spinning Solution
3.3. Preparation and Characterization of HBP-HTC/TPU Fiber Membranes
4. Conclusions
- (1)
- The HBP-HTC/TPU fiber membrane was fabricated via a single-step electrospinning process. When a spinning voltage of 22 kV and a drum rotation speed of 100 rpm were utilized, the resultant average fiber diameter was approximately 1.66 μm, and the fibers were characterized by an optimal diameter distribution. This revealed an interwoven mesh structure under SEM.
- (2)
- Upon surpassing an HBP-HTC content of 1500 mg/kg within the TPU fiber membrane, the antibacterial efficacy against both E. coli and S. aureus reaches 99.99%, coupled with a filtration efficiency of 99.9%, and exhibits a hydrostatic pressure exceeding 16,758 Pa. Furthermore, the moisture vapor transmission rate reaches 2711.0 g·(m2·d)−1. Consequently, the direct incorporation of the hyperbranched polymer quaternary ammonium salt into TPU followed by electrospinning yields a fiber membrane endowed with superior protective attributes, thereby holding promising potential for application in the domain of medical protective textiles.
Author Contributions
Funding
Institutional Review Board Statement
Informed Consent Statement
Data Availability Statement
Conflicts of Interest
References
- Cook, T.M. Personal protective equipment during the coronavirus disease (COVID) 2019 pandemic—A narrative review. Anaesthesia 2020, 75, 920–927. [Google Scholar] [CrossRef] [PubMed]
- Zhou, Z.; Zhou, S.; Zhang, X.; Zeng, S.; Xu, Y.; Nie, W.; Zhou, Y.; Xu, T.; Chen, P. Quaternary Ammonium Salts: Insights into Synthesis and New Directions in Antibacterial Applications. Bioconjugate Chem. 2023, 34, 302–325. [Google Scholar] [CrossRef] [PubMed]
- Jennings, M.C.; Minbiole, K.P.C.; Wuest, W.M. Quaternary Ammonium Compounds: An Antimicrobial Mainstay and Platform for Innovation to Address Bacterial Resistance. ACS Infect. Dis. 2015, 1, 288–303. [Google Scholar] [CrossRef] [PubMed]
- Zhao, J.; Wang, L.; Xiao, J.; Tao, M.; Zhang, W. Removal of anionic azo dyes from aqueous solutions by quaternary ammonium salt-functionalized fibers with adjustable surface microenvironments. React. Funct. Polym. 2020, 154, 104684. [Google Scholar] [CrossRef]
- Qiao, S.; Liu, Q.; Fan, Z.; Tong, Q.; Cai, L.; Fu, Y. Magnetic Hyperbranched Molecular Materials for Treatment of Oily Sewage Containing Polymer in Oilfield Compound Flooding. Front. Chem. 2022, 10, 865832. [Google Scholar] [CrossRef] [PubMed]
- Ahmadi, Y.; Kim, K.-H. Hyperbranched polymers as superior adsorbent for the treatment of dyes in water. Adv. Colloid Interface Sci. 2022, 302, 102633. [Google Scholar] [CrossRef] [PubMed]
- Zhao, W.; Wang, M.; Yao, Y.; Cheng, Z.; Shen, Y.; Zhang, Y.; Tao, J.; Xiong, J.; Cao, H.; Zhang, D. Hyperbranched Polymer Induced Antibacterial Tree-Like Nanofibrous Membrane for High Effective Air Filtration. Macromol. Rapid Commun. 2024, 45, e2300685. [Google Scholar] [CrossRef] [PubMed]
- Qiu, Z.-L.; Yu, W.-H.; Shen, Y.-J.; Zhu, B.-K.; Fang, L.-F. Cationic hyperbranched poly(amido-amine) engineered nanofiltration membrane for molecular separation. J. Membr. Sci. 2021, 629, 119275. [Google Scholar] [CrossRef]
- Sorci, M.; Fink, T.D.; Sharma, V.; Singh, S.; Chen, R.; Arduini, B.L.; Dovidenko, K.; Heldt, C.L.; Palermo, E.F.; Zha, R.H. Virucidal N95 Respirator Face Masks via Ultrathin Surface-Grafted Quaternary Ammonium Polymer Coatings. ACS Appl. Mater. Interfaces 2022, 14, 25135–25146. [Google Scholar] [CrossRef]
- Almeida e Silva, T.; Gorup, L.F.; de Araújo, R.P.; Fonseca, G.G.; Martelli, S.M.; de Oliveira, K.M.P.; Faraoni, L.H.; de Arruda, E.G.R.; Gomes, R.A.B.; da Silva, C.H.M.; et al. Synergy of Biodegradable Polymer Coatings with Quaternary Ammonium Salts Mediating Barrier Function against Bacterial Contamination and Dehydration of Eggs. Food Bioprocess Technol. 2020, 13, 2065–2081. [Google Scholar] [CrossRef]
- Li, H.; Chen, X.; Lu, W.; Wang, J.; Xu, Y.; Guo, Y. Application of Electrospinning in Antibacterial Field. Nanomaterials 2021, 11, 1822. [Google Scholar] [CrossRef] [PubMed]
- Karagoz, S.; Kiremitler, N.B.; Sarp, G.; Pekdemir, S.; Salem, S.; Goksu, A.G.; Onses, M.S.; Sozdutmaz, I.; Sahmetlioglu, E.; Ozkara, E.S.; et al. Antibacterial, Antiviral, and Self-Cleaning Mats with Sensing Capabilities Based on Electrospun Nanofibers Decorated with ZnO Nanorods and Ag Nanoparticles for Protective Clothing Applications. ACS Appl. Mater. Interfaces 2021, 13, 5678–5690. [Google Scholar] [CrossRef] [PubMed]
- Chen, H.; Zhang, J.; Wu, H.; Li, Y.; Li, X.; Zhang, J.; Huang, L.; Deng, S.; Tan, S.; Cai, X. Fabrication of a Cu Nanoparticles/Poly(ε-caprolactone)/Gelatin Fiber Membrane with Good Antibacterial Activity and Mechanical Property via Green Electrospinning. ACS Appl. Bio Mater. 2021, 4, 6137–6147. [Google Scholar] [CrossRef] [PubMed]
- Xia, Y.; He, L.; Feng, J.; Xu, S.; Yao, L.; Pan, G. Waterproof and Moisture-Permeable Polyurethane Nanofiber Membrane with High Strength, Launderability, and Durable Antimicrobial Properties. Nanomaterials 2022, 12, 1813. [Google Scholar] [CrossRef] [PubMed]
- Chen, Q.; Zhao, K.; Li, G.; Luo, J.; Li, X.; Zeng, Y.; Wang, X.-M. Highly Permeable Polylactic Acid Membrane Grafted with Quaternary Ammonium Salt for Effective and Durable Water Disinfection. ACS Appl. Mater. Interfaces 2022, 14, 43741–43748. [Google Scholar] [CrossRef] [PubMed]
- Zhang, F.; Chen, Y.; Ling, H.; Zhang, D. Synthesis of HBP-HTC and Its Application to Cotton Fabric as an Antimicrobial Auxiliary. Fibers Polym. 2009, 10, 141–147. [Google Scholar] [CrossRef]
- Zhang, D.; Chen, L.; Zang, C.; Chen, Y.; Lin, H. Antibacterial cotton fabric grafted with silver nanoparticles and its excellent laundering durability. Carbohydr Polym. 2013, 92, 2088–2094. [Google Scholar] [CrossRef] [PubMed]
- Tian, W.; Fan, X.D.; Liu, Y.Y.; Jiang, M.; Huang, Y.; Kong, J. β-Cyclodextrin polymer brushes based on hyperbranched polycarbosilane: Synthesis and characterization. J. Polym. Sci. Part A Polym. Chem. 2008, 46, 5036–5052. [Google Scholar] [CrossRef]
- Li, X.; Yuan, C.; Zhou, H.; Gao, G.; He, J.; Li, Y.; Liu, Z.; Feng, M.; Zhou, T.; Sun, H.; et al. Enhanced piezoelectric performance of core–shell structured PVDF/PC nanofiber films via electrospinning. Mater. Lett. 2024, 370, 136848. [Google Scholar] [CrossRef]
- Lo, N.K.; Sutanto, H.; Jonathan, F.; Meiza, H.; Salim, F.M.; Sutanto, A.H.R.; Arifin, Z. Effects of copper and bismuth dopants on PVA/NBT film as an X-ray dosimeter. Mater. Chem. Phys. 2024, 319, 129362. [Google Scholar] [CrossRef]
- Lan, X.; Luo, T.; Zhong, Z.; Huang, D.; Liang, C.; Liu, Y.; Wang, H.; Tang, Y. Green cross-linking of gelatin/tea polyphenol/ε-poly (L-lysine) electrospun nanofibrous membrane for edible and bioactive food packaging. Food Packag. Shelf Life 2022, 34, 100970. [Google Scholar] [CrossRef]
- Kang, L.; Huang, S.; Qin, X.; Gao, X.; Li, Y.; Zhang, X. Ag Nanoparticles-Decorated PVDF Nanofiber/Net Membranes with Enhanced Filtration and Antibacterial Efficiency for Personal Protective Equipment. ACS Appl. Nano Mater. 2024, 7, 9252–9261. [Google Scholar] [CrossRef]
- Li, L.; Zhang, C.; Tian, L.; Wu, Z.; Wang, D.; Jiao, T. Preparation and Antibacterial Properties of a Composite Fiber Membrane Material Loaded with Cationic Antibacterial Agent by Electrospinning. Nanomaterials 2023, 13, 583. [Google Scholar] [CrossRef] [PubMed]
- Liu, R.; Qu, M.; Qiu, X.; Wang, H.; Fan, M.; Zhang, A.; Chen, Q.; Bin, Y. Poly (ethylene terephthalate) nonwoven fabrics-based membranes modified by electrospinning of thermoplastic polyurethane, nano SiO2 and Ag particles as medical packing materials. Packag. Technol. Sci. 2022, 35, 557–567. [Google Scholar] [CrossRef]
- Feng, J.; Xu, S.; Pan, G.; Yao, L.; Guan, Y.; Zhou, L.; Cui, L.; Yang, Z. Clean preparation of washable antibacterial polyester fibers by high temperature and high pressure hydrothermal self-assembly. Nanotechnol. Rev. 2021, 10, 1740–1751. [Google Scholar] [CrossRef]
- Fu, L.; Zhang, S.; Wang, R.; Cao, G.; Jing, M.; Zhang, Y.; Zhang, Z. Hot-pressing design of tubular polyester nonwoven lining material for pipeline rehabilitation. J. Ind. Text. 2021, 51 (Suppl. S3), 4603S–4621S. [Google Scholar] [CrossRef]
- Makwana, U.C.; Singala, K.J.; Patankar, R.B.; Singh, S.C.; Gupta, V.K. Propylene polymerization using supported Ziegler–Natta catalyst systems with mixed donors. J. Appl. Polym. Sci. 2011, 125, 896–901. [Google Scholar] [CrossRef]
- Ding, H.; Jiang, Y.; Wang, Y.; Ju, H.; Geng, T. Distributions of counterions on adsorption and aggregation behavior of Gemini quaternary ammonium salt. J. Mol. Liq. 2021, 342, 117495. [Google Scholar] [CrossRef]
- Ding, F.; Zhong, Y.; Wu, S.; Liu, X.; Zou, X.; Li, H. Synthesis and characterization of quaternized agar in KOH/urea aqueous solution. New J. Chem. 2020, 44, 17062–17069. [Google Scholar] [CrossRef]
- Le, B.; Omran, N.; Hassanin, A.H.; Kandas, I.; Gamal, M.; Shehata, N.; Shyha, I. Flexible piezoelectric PVDF/TPU nanofibrous membranes produced by solution blow spinning. J. Mater. Res. Technol. 2023, 24, 5032–5041. [Google Scholar] [CrossRef]
- El-Katori, E.E.; Nessim, M.I.; Deyab, M.A.; Shalabi, K. Electrochemical, XPS and theoretical examination on the corrosion inhibition efficacy of stainless steel via novel imidazolium ionic liquids in acidic solution. J. Mol. Liq. 2021, 337, 116467. [Google Scholar] [CrossRef]
- Liu, X.; Ge, X.; Liu, M.; Zhou, K.; Zhu, Q.; Chen, D.; Liu, C.; Wang, C.; Liu, X.; Tang, G. Facile fabrication of NiAl-LDH and its application in TPU nanocomposites targets for reducing fire hazards. Plast. Rubber Compos. 2021, 50, 285–298. [Google Scholar] [CrossRef]
- Zhang, J. Platelet adhesive resistance of segmented polyurethane film surface-grafted with vinyl benzyl sulfo monomer of ammonium zwitterions. Biomaterials 2003, 24, 4223–4231. [Google Scholar] [CrossRef] [PubMed]
- Golczak, S.; Kanciurzewska, A.; Fahlman, M.; Langer, K.; Langer, J. Comparative XPS surface study of polyaniline thin films. Solid State Ionics 2008, 179, 2234–2239. [Google Scholar] [CrossRef]
- Li, X.; Wang, Z.; Wang, J.; Liu, J.; Li, C. Preparation and properties of TPU micro/nanofibers by a laser melt-electrospinning system. Polym. Eng. Sci. 2014, 54, 1412–1417. [Google Scholar] [CrossRef]
- Li, Y.; Zhang, C.; Zhu, L.F.; Ahmad, Z.; Li, J.S.; Chang, M.W. Elastic antibacterial membranes comprising particulate laden fibers for wound healing applications. J. Appl. Polym. Sci. 2018, 136, 47105. [Google Scholar] [CrossRef]
- Wu, Z.; Deng, X.; Yu, X.; Gu, J.; El-Bahy, Z.M.; Mersal, G.A.M.; Zhang, J.; Alhadhrami, A.; Xu, H.; Guo, N.; et al. Electrospun thermoplastic polyurethane membrane decorated with carbon nanotubes: A platform of flexible strain sensors for human motion monitoring. Polymer 2024, 303, 127120. [Google Scholar] [CrossRef]

| HBP-HTC Content/mg·kg−1 | Inhibition Rate of E. coli/% | Inhibition Rate of S. aureus/% |
|---|---|---|
| 0 | 0 | 0 |
| 500 | 13.84 | 12.19 |
| 1000 | 42.19 | 39.76 |
| 1250 | 99.98 | 99.94 |
| 1500 | 99.99 | 99.99 |
| 1750 | 99.99 | 99.99 |
| 2000 | 99.99 | 99.99 |
| Sample | Filtration Efficacy/% | Water Resistance/Pa | Moisture Vapor Permeability/[g·(m2·d)−1] |
|---|---|---|---|
| Pure TPU fiber membrane | 99.9 | >16,758 | 2891.9 |
| HBP-HTC/TPU fiber membrane | 99.9 | >16,758 | 2711.0 |
Disclaimer/Publisher’s Note: The statements, opinions and data contained in all publications are solely those of the individual author(s) and contributor(s) and not of MDPI and/or the editor(s). MDPI and/or the editor(s) disclaim responsibility for any injury to people or property resulting from any ideas, methods, instructions or products referred to in the content. |
© 2024 by the authors. Licensee MDPI, Basel, Switzerland. This article is an open access article distributed under the terms and conditions of the Creative Commons Attribution (CC BY) license (https://creativecommons.org/licenses/by/4.0/).
Share and Cite
Zhu, J.; Guo, Y.; Yao, L.; Pan, G.; Zhang, D.; Yang, J. Preparation and Property Analysis of Antibacterial Fiber Membranes Based on Hyperbranched Polymer Quaternary Ammonium Salts. Materials 2024, 17, 3761. https://doi.org/10.3390/ma17153761
Zhu J, Guo Y, Yao L, Pan G, Zhang D, Yang J. Preparation and Property Analysis of Antibacterial Fiber Membranes Based on Hyperbranched Polymer Quaternary Ammonium Salts. Materials. 2024; 17(15):3761. https://doi.org/10.3390/ma17153761
Chicago/Turabian StyleZhu, Jiehui, Ying Guo, Lirong Yao, Gangwei Pan, Desuo Zhang, and Jianwei Yang. 2024. "Preparation and Property Analysis of Antibacterial Fiber Membranes Based on Hyperbranched Polymer Quaternary Ammonium Salts" Materials 17, no. 15: 3761. https://doi.org/10.3390/ma17153761
APA StyleZhu, J., Guo, Y., Yao, L., Pan, G., Zhang, D., & Yang, J. (2024). Preparation and Property Analysis of Antibacterial Fiber Membranes Based on Hyperbranched Polymer Quaternary Ammonium Salts. Materials, 17(15), 3761. https://doi.org/10.3390/ma17153761

